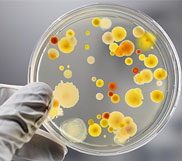

Explore our course guides to find out everything you need to know about applying for the subject of your choice.

A degree in accounting can lead on to many exciting career opportunities, and that doesn’t just mean becoming an accountant! Here's our advice on applying for a degree in Accounting.
View all Accounting articles...

Architecture students develop enhanced, and highly desirable, creative, technical and design-based skills. As well as a career in architecture, there are a number of other opportunities open to you.
View all Architecture articles...
If you’re imaginative, passionate about art, and can demonstrate your artistic talents with a strong portfolio then a creative course such as Art and Design would be a good option.
View all Art & Design articles...
Biology, or Biological Sciences as it is sometimes known, is a broad area that offers graduates many exciting opportunities after they’ve completed their degree.

Degree courses such as Business, Management, and Accountancy are generally open to students with a variety of A Level subjects.

In the digital age computer based degree courses have become increasingly popular a degree in this field could lead to an interesting, and well-paid, career after graduation.
View all Computing & IT articles...

A Dentistry degree gives you a broad education in all aspects of the dental profession including human disease, medical science, clinical studies, and clinical dentistry.
View all Dentistry articles...

If you’re a talented mathematician and have an interest in using statistical analysis in relation to economic and financial data then an Economics degree might be the right choice for you.

There are many areas of Engineering and plenty of opportunity to specialise so as an Engineering graduate the world is your oyster.
View all Engineering articles...
Although a History degree doesn’t lead to an obvious career you’ll learn many valuable skills that are highly prized by employers from all industries.
Whether you dream of being on television or hope to run an online magazine there is a career in journalism for you. However, media is a very competitive industry and formal study is valuable.
View all Journalism articles...

Covering a wide range of legal practice, including Criminal Law, Business Law, Civil Law and Human Rights Legislation, to name but a few, there are many areas in which you may choose to specialise once you have completed your original Law degree.

A Management degree provides a foundation in topics relating to business, finance, economics and marketing. Most universities offer a very practical Management degree, including work placements.
View all Management articles...

Marketing is one of the most popular degrees, making entry level routes into marketing roles extremely competitive, but there are many career paths you can take with your Marketing degree.
View all Marketing articles...

There is a demand for mathematicians across many sectors, including roles in the petroleum and nuclear industries, medicine and IT, many forms of engineering and government departments.
View all Mathematics articles...
Medicine is a very popular and extremely competitive course so you’ll need to be at the top of your game and have all your extra-curricular ducks in a row to get on to a medical course.
A degree in Nursing can lead to an exciting and rewarding career that could take you all over the world. There is also a lot of opportunity for career progression and specialised roles.

At the heart of Physics is the desire to find out how the world works. This is done by carrying out experiments and attempting to describe the results with the aim of testing theories.

Psychology is a broad degree subject covering a range of topics and subjects including criminology, philosophy, the social sciences, and humanities.
View all Psychology articles...

Social Studies covers a number of disciplines, from Social Policy and Community Research to Youth Studies.
View all Social Studies articles...

The majority of Social Work graduates go on to become social workers. However, there are a number of career paths you could choose after graduation.
View all Social Work articles...

You’ll learn about the human anatomy, sports psychology, and how to treat damaged muscles. You’ll also learn the management side of sports, looking at finance, marketing, and other commercial issues.
View all Sports & Leisure articles...

Most undergraduates who take a Teacher Training degree will want to become a teacher. However, this isn’t the only thing you can do with a Teacher Training degree.
View all Teacher Training articles...

Veterinary Medicine is a popular degree option which can lead to a fulfilling career, and is a great option for animal lovers! Here's our advice on applying for a degree in Veterinary Medicine.
View all Veterinary Medicine articles...